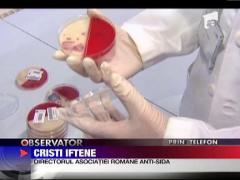
O barmanita, concediata pentru ca este infectata cu HIV

Noua tulpină a virusului HIV îi sperie pe medici
Noua tulpină a virusului HIV îi sperie pe mediciO nouă tulpină a virusului HIV a fost descoperită în România. Anunţul a fost făcut de specialiştii de la Bucureşti, care au...
pe 26.11.2013 la 19:48
Charlize Theron, intalnire cu presedintele Africii de Sud pentru combaterea virusului HIV
Charlize Theron, intalnire cu presedintele Africii de Sud pentru combaterea virusului HIVCharlize Theron s-a intalnit cu presedintele tarii sale natale, Africa de Sud, pentru a discuta despre masurile de combatere a...
pe 30.07.2013 la 07:48
Un tanar orfan a fost nevoit sa renunte la munca, dupa ce a aflat ca are SIDA
Un tanar orfan a fost nevoit sa renunte la munca, dupa ce a aflat ca are SIDASufera de doua boli crunte, pentru care nu exista tratament: SIDA si indiferenta oamenilor. Un tanar de 27 de ani a aflat acum un an...
pe 23.04.2013 la 19:14
SPECIAL!!! Afla AICI ce sanse are un seropozitiv sa-si gaseasca de lucru!
SPECIAL!!! Afla AICI ce sanse are un seropozitiv sa-si gaseasca de lucru!De cand eram mici, parintii ne invatau sa spunem intotdeauna adevarul! Pe masura ce am crescut, insa, ajungem la concluzia ca, din...
pe 04.04.2013 la 20:04
SOARTA NECRUTATOARE: Drama unei romance adoptata in SUA
SOARTA NECRUTATOARE: Drama unei romance adoptata in SUASoarta se arata necrutatoare cu o orfana romanca. A fost diagnosticata cu HIV la scurt timp dupa ce a ajuns in America, in grija...
pe 04.04.2013 la 19:43
7.000 de pacienti ai unui dentist american, supusi riscului de a fi infectati cu HIV
7.000 de pacienti ai unui dentist american, supusi riscului de a fi infectati cu HIVUn stomatolog din statul american Oklahoma a supus riscului infectarii cu HIV si cu alte boli infectioase aproape 7.000 de pacienti....
pe 29.03.2013 la 15:37
India: Flash-mob menit sa convinga prostituatele sa se apere de SIDA
India: Flash-mob menit sa convinga prostituatele sa se apere de SIDAZeci de studenti de la universitatea din Delhi au participat la un flash mob intr-unul din cartierele "cu felinare rosii" din...
pe 14.02.2013 la 07:50
Si-a imbolnavit iubitul cu virusul HIV in mod constient!
Si-a imbolnavit iubitul cu virusul HIV in mod constient!Si-a imbolnavit iubitul cu virusul HIV iar acum risca sa faca doi ani si jumatate de inchisoare. Este povestea incredibila a unei...
pe 13.02.2013 la 19:19
Cei mai periculosi virusi din istoria omenirii, recreati in sticla
Cei mai periculosi virusi din istoria omenirii, recreati in sticlaUn artist britanic a recreat cei mai periculosi virusi din istoria omenirii, in sticla. Vizitatorii expozitiei sale pot privi...
pe 11.02.2013 la 07:28
Copil vindecat de leucemie cu ajutorul unei forme dezactivate a virusului HIV
Copil vindecat de leucemie cu ajutorul unei forme dezactivate a virusului HIVReusita medicala incredibila in Statele Unite. Medicii de aici au reusit sa vindece complet o fetita de 7 ani care suferea de o...
pe 12.12.2012 la 13:58
O consultatie la dentist sau o programare la cosmetica sunt misiuni imposibile pentru o persoana infectata cu HIV
O consultatie la dentist sau o programare la cosmetica sunt misiuni imposibile pentru o persoana infectata cu HIVPana unde merge discriminarea in cazul persoanelor diagnosticate cu HIV? Ca sa afle asta, reporterii Observator au facut un...
pe 02.12.2012 la 19:08
Romania, pe primul loc la infectiile cu HIV in randul consumatorilor de droguri
Romania, pe primul loc la infectiile cu HIV in randul consumatorilor de droguriSituatie alarmanta in Romania drogurilor. Un raport European ne plaseaza pe primul loc la infectiile cu HIV in ultimii doi ani....
pe 24.11.2012 la 16:28
Aproximativ o mie de turisti ar fi intretinut relatii sexuale cu prostituata infectata cu HIV
Aproximativ o mie de turisti ar fi intretinut relatii sexuale cu prostituata infectata cu HIVO mie de turisti in pericol sa se fi infectat cu HIV - e un motiv cat se poate de serios pentru masuri extreme la malul marii....
pe 12.08.2012 la 19:20
Prostituate infectate cu HIV pe litoral! Peste 1000 de barbati ar putea fi infectati!
Prostituate infectate cu HIV pe litoral! Peste 1000 de barbati ar putea fi infectati!Peste o mie de turisti care si-au condimentat concediul la malul marii cu partide de sex pe bani ar putea fi infectati cu virusul...
pe 11.08.2012 la 19:08
Spital din Danemarca, focar de infectie cu HIV si hepatita
Spital din Danemarca, focar de infectie cu HIV si hepatitaPeste 700 de fosti pacienti ai unui spital din Danemarca au primit neplacuta veste ca ar putea fi infectati cu HIV sau hepatita, din...
pe 20.07.2012 la 07:37
Numarul pacientilor infectati cu HIV in urma injectarii de droguri a crescut de zece ori
Numarul pacientilor infectati cu HIV in urma injectarii de droguri a crescut de zece oriIn Romania prioritatile se stabilesc in functie de cele sfinte. Numarul pacientilor infectati cu HIV in urma injectarii de droguri a...
pe 19.07.2012 la 19:25
Balul Vietii, organizat la Viena
Balul Vietii, organizat la VienaCea de-a 20-a editiei a Balului Vietii, cel mai mare eveniment caritabil pentru persoanele cu HIV/SIDA, a fost organizata, ieri, la...
pe 21.05.2012 la 07:39
Primul tratament de preventie a infectiei cu virusul HIV va fi scos pe piata
Primul tratament de preventie a infectiei cu virusul HIV va fi scos pe piataE agitatie mare in lumea medicala. Specialistii americani au anuntat ca vor scoate pe piata, luna viitoare, primul tratament de...
pe 14.05.2012 la 16:33
O romanca printre prostituatele din Grecia depistate cu virusul HIV
O romanca printre prostituatele din Grecia depistate cu virusul HIVO romanca este implicata in scandalul prostituatelor seropozitive din Grecia. Anchetatorii eleni tocmai au descoperit ca este, si...
pe 09.05.2012 la 19:37
24 prostituate infectate cu HIV au imbolnavit mii de barbati
24 prostituate infectate cu HIV au imbolnavit mii de barbati24 dame de companie au provocat o adevarata isterie in Grecia. Mii de barbati amatori de senzatii interzise, printre care si romani,...
pe 05.05.2012 la 19:10
Un pas important in lupta cu virusul HIV
Un pas important in lupta cu virusul HIVOamenii de stiinta au mai facut un pas spre elaborarea unui tratament pentru SIDA. O echipa a Universitatii din California a aratat,...
pe 14.04.2012 la 10:00
O barmanita, concediata pentru ca este infectata cu HIV
O barmanita, concediata pentru ca este infectata cu HIVO barmanita din Constanta a aflat de la seful ei ca ar putea fi infectata cu HIV! Dupa care a fost data afara. Tanara tocmai facuse...
pe 16.12.2011 la 19:27
Efectele crizei in Grecia:depresii, sinucideri, droguri, HIV
Efectele crizei in Grecia:depresii, sinucideri, droguri, HIVGrecia nu are probleme numai cu banii, oamenii sunt foarte deprimati si pun tot mai putin pret pe viata lor. Un semnal este faptul...
pe 29.11.2011 la 07:06
Bolnavi de HIV ucisi de Biserica
Bolnavi de HIV ucisi de BisericaUn caz revoltator socheaza Marea Britanie. 6 oameni au murit dupa ce la biserica pe care o frecventau li s-a spus sa nu mai ia...
pe 25.11.2011 la 19:21
Casa protejata cu virusul HIV
Casa protejata cu virusul HIVO doctorita din Brazilia a gasit o metoda mai putin ortodoxa ca sa scape de hoti. Femeia a montat pe gardul din fata casei mai multe...
pe 23.08.2011 la 07:58
Vrancea: Angajat muscat de o fosta pacienta infectata cu HIV
Vrancea: Angajat muscat de o fosta pacienta infectata cu HIVIsi risca sanatatea pentru cateva sute de lei! Angajatii unui centru de ingrijire a persoanelor infectate cu virusul hiv au fost...
pe 01.07.2011 la 16:14
Cel mai pazit detinut din SUA
Cel mai pazit detinut din SUANici inchisoarea, nici sfarsitul carierei nu reprezinta adevarata problema pentru cel mai mare bancher al lumii! Menajera pe care a...
pe 18.05.2011 la 19:39
Mars anti-SIDA
Mars anti-SIDAAproximativ zece mii de romani, majoritatea cu varste intre 19 si 25 de ani se lupta cu virusul HIV. In fiecare an multi dintre ei...
pe 16.05.2011 la 07:22
Vindecat de HIV
Vindecat de HIVVirusul HIV este vindecabil. Cea mai buna dovada este un american stabilit in Germania. Barbatul suferea si de leucemie, motiv...
pe 15.12.2010 la 13:48
Acuzat pe jumatate
Acuzat pe jumatateBotosaneanul care si-a imbolnavit sotia cu HIV a fost trimis in judecata. Insa legea nu-l va pedepsi pentru ca femeia a murit, ci...
pe 06.12.2010 la 06:28
Succes in lupta cu SIDA
Succes in lupta cu SIDADescoperire revolutionara in lupta cu SIDA facuta de specialistii americani. Combinatia dintre doua medicamente cu administrare...
pe 24.11.2010 la 13:58
Circumcizia alunga HIV
Circumcizia alunga HIVCircumcizia ar putea preveni infectarea cu virusul HIV. Asta sustine o echipa de medici australieni.
pe 23.09.2010 la 19:58
Tratament cu HIV
Tratament cu HIVHIV poate salva vieti. Au demonstrat-o cativa medici francezi, care au folosit o varianta inofensiva a virusului pentru un...
pe 20.09.2010 la 13:40
In pragul epidemiei de SIDA
In pragul epidemiei de SIDARomania este la un pas de o epidemie HIV/SIDA ! Asa vad jurnalistii de la Time Magazin viitorul tarii noatre, dupa ce mai multe...
pe 14.09.2010 la 06:30
Agresiune cu virusul HIV
Agresiune cu virusul HIVO cantareata din Germania este judecata, in aceste zile, pentru contaminarea fostilor sai iubiti cu virusul HIV. In fata...
pe 17.08.2010 la 07:44
Balul vietii
Balul vietiiInima Vienei a batut, aseara, pentru bolnavii de SIDA. In capitala Austriei a avut loc Balul Vietii, dedicat strangerii de fonduri...
pe 18.07.2010 la 16:33
O gluma periculoasa
O gluma periculoasaUn gest necugetat facut de doi elevi, a panicat toata scoala din localitatea sibiana Vestem. Au adus la scoala un aparat pentru...
pe 28.04.2010 la 07:44